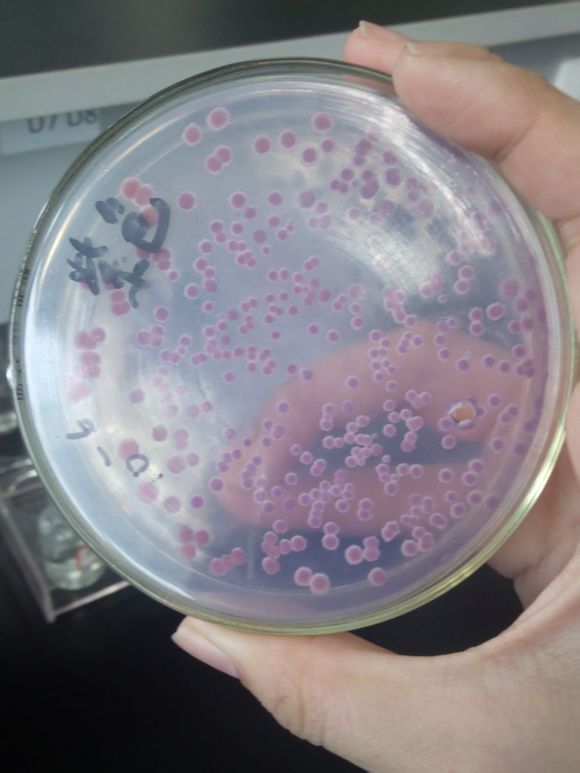
直丝紫链霉菌(菌种)

5406链霉菌

链霉菌
图片尺寸595x793
灰色链霉菌
图片尺寸640x480
一种链霉菌及其在防治甘蔗凤梨病中的应用
图片尺寸604x604
链孢霉对灵芝危害及防治方法
图片尺寸500x356
白色链霉菌
图片尺寸400x300
链孢霉正确预防措施和治疗方案
图片尺寸1080x1439
科学家解析链霉菌高产菌株高效绿色构建(1)
图片尺寸465x310
链孢霉正确预防措施和治疗方案
图片尺寸1080x1439
产色链霉菌
图片尺寸576x430
链霉菌属
图片尺寸290x228
灰色链霉菌成美新泽西州"州微生物"
图片尺寸720x540
一种白色链霉菌x-18及利用该菌生产ε-聚赖氨酸的方法与流程
图片尺寸378x284
金色链霉菌
图片尺寸268x178
一株灰色链霉菌hl-50及其复合菌剂与应用的制作方法
图片尺寸1000x1000
一株产抗癌活性物质的公牛链霉菌菌株筛选方法和鉴定方法与流程
图片尺寸961x959
链霉菌是真核还是原核-最新链霉菌是真核还是原核整理解答
图片尺寸800x320
链霉菌b221与地衣芽孢杆菌nj省略4111固体混合发酵工艺的优化尹浩力
图片尺寸470x408
这是什么霉菌
图片尺寸4160x2336
直丝紫链霉菌(菌种)
图片尺寸580x773
放线菌:主要分布在链霉菌属(streptomyces) 藻类:主要分布在小球藻属
图片尺寸1080x810